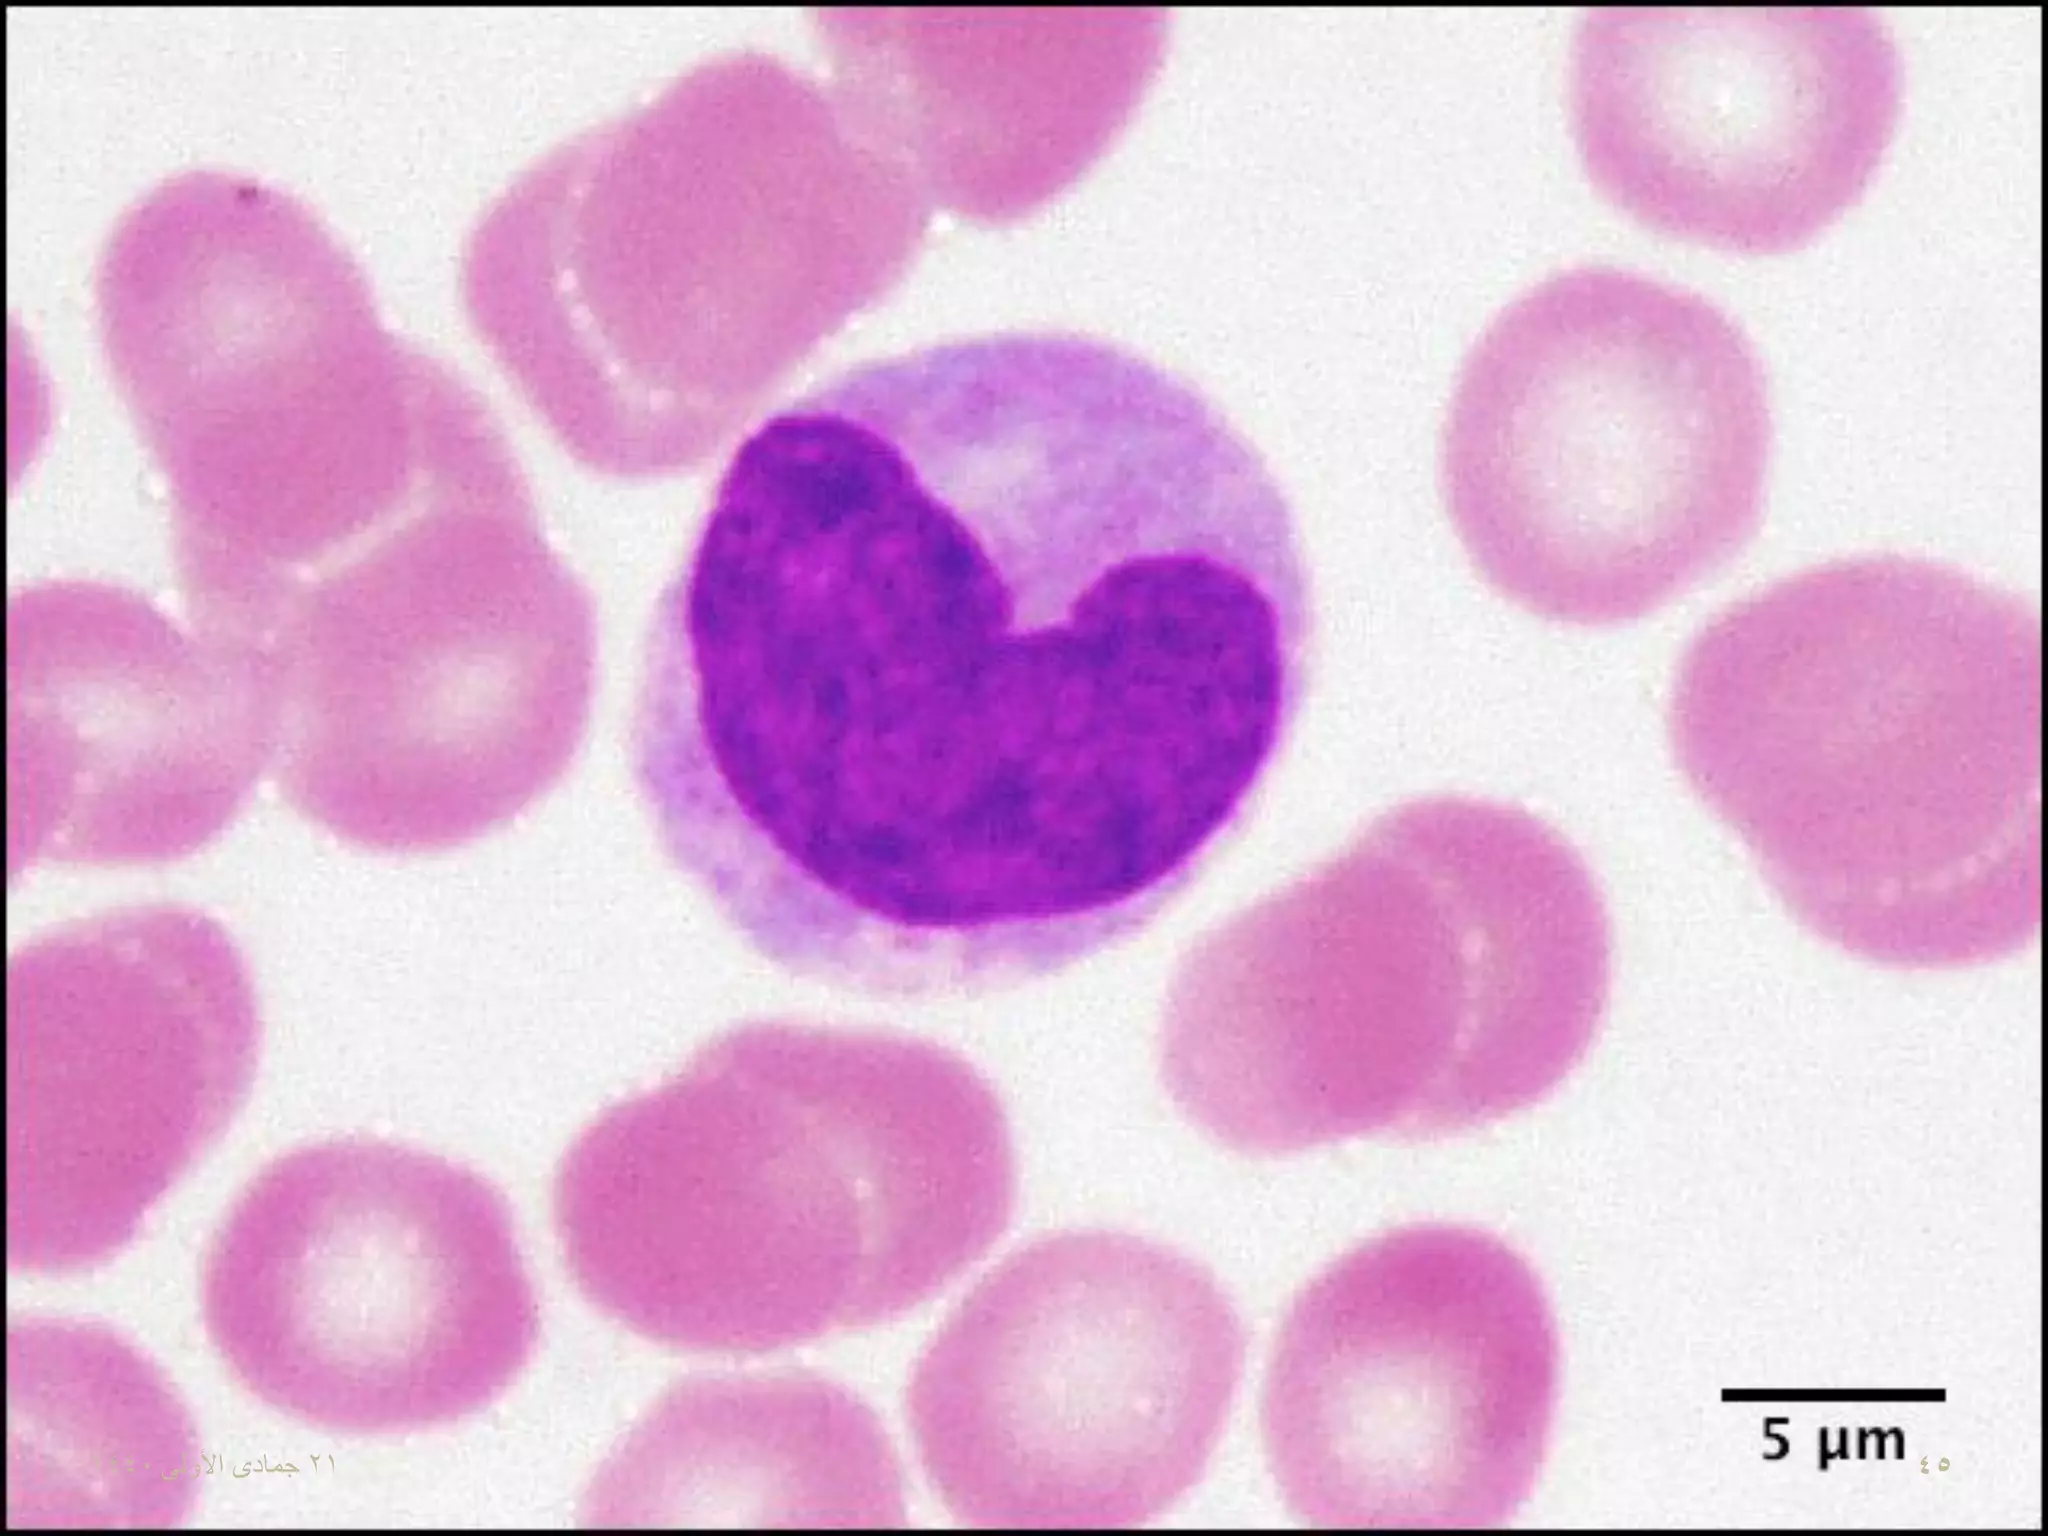

Моноцитоз что это
Знаешь что этот тренд 2025 года
Дом с бассейном в пятигорске
Мцко это для чего
Длинные волосы на свадьбу
Лечо на зиму без масла и уксуса
Ювентус выигрывает
Window to usb
Топливный насос мондео 3
Агутин слушай меня
Процентный калькулятор рассчитать
Микс сюрпризов по мультикам мультяшный микс
Рада что ты мне писал
Том круз с русской
Моноцитоз что это 107 фото